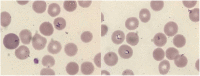

Hemagophagocytic lymphohistiocytosis associated with recurrent Babesiosis with Lyme disease co-infection in an immunocompromised host on anti-CD20 monoclonal antibody therapy: A case report
- PMID: 35855942
- PMCID: PMC9287144
- DOI: 10.1016/j.idcr.2022.e01570
Hemagophagocytic lymphohistiocytosis associated with recurrent Babesiosis with Lyme disease co-infection in an immunocompromised host on anti-CD20 monoclonal antibody therapy: A case report
Abstract
In the Northeastern United States, a nationally notifiable emerging infectious disease caused by a protozoan infecting erythrocytes is endemic. Transmitted by a deer tick, Ixodes scapularis, this protozoan, Babesia microti, has a complex life cycle including multiple mammalian hosts with humans affected as a dead end reservoir. Although humans are not necessary for the survival of this protozoan, if human erythrocytes are infected by it, especially in a host that is immunocompromised, devastating clinical illness with a significant risk of mortality occurs. Erythrocytic infection of the human host causes many pathogenic changes within the human body, leading to red blood cell destruction and release of pro inflammatory cytokines (3). This pro-inflammatory cascade can very rarely lead to a cycle of further erythrocytic destruction through development of a rare syndrome with high mortality, hemagophagocytic lymphohistocytosis (HLH), which requires early recognition and diagnosis for treatment. This case discusses infection in an immunocompromised host with Babesiosis with complications of HLH and co-infection with Lyme disease requiring multiple diagnostic and therapeutic decisions.
Keywords: Babesiosis; Hemagophagocytic lymphohistiocytosis; Infectious Complication with anti-CD20 Antibody Therapy; Lyme and Babesiosis co-infection; Tick-borne disease.
© 2022 The Authors.
Conflict of interest statement
The authors have no conflicts of interest to declare.
Figures

References
Publication types
LinkOut - more resources
Full Text Sources